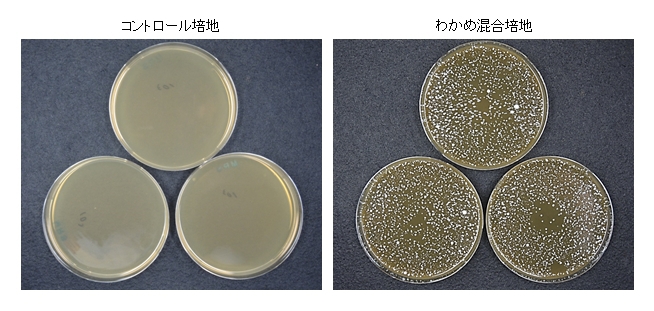

2017.03.19(月) |
「わかめ摂取がヒトの便通と腸内環境に与える影響」を 日本農芸化学会2018年度大会で発表、わかめの摂取で おなかのビフィズス菌の割合がアップ(理研ビタミン) |
---|
ふえるわかめちゃん®や、わかめスープ、ノンオイルドレッシングを販売する理研ビタミン(株)(本社東京都千代田区、山木一彦代表取締役社長)は、わかめを摂取することにより排便状況が改善され、おなかの中でビフィズス菌の占有率が増えることをヒト試験で確認した。この研究内容は、3月15日より開催された日本農芸化学会2018年度大会(演題番号2A13p11)にて発表した。
URL:http://www.rikenvitamin.jp/corporate/technology/presentation.html
海藻はおよそ97%の人が「健康的である」というイメージを強くもっている食材(自社調べ)であるにもかかわらず、その健康効果については未解明な部分が多いのが実情だ。
理研ビタミンはこれまで、わかめの健康効果を明らかにすべく研究を重ね、血圧やコレステロールに対する影響など発表してきた文献1)。近年の研究から、生活習慣病の発症に腸内細菌が関与していることを示す研究が多く発表されていることなどから、今回はわかめの便通と腸内環境に与える影響をヒト試験で調べた。
【方法】
被験者 :週の排便日数が3-5日/週の便秘気味の女性21名の方
試験期間 :わかめを食べる前の2週間と、食べている2週間の合計4週間
試験食 :乾燥カットわかめ4g/日
※乾燥カットわかめは水戻しして食べる事以外、特に食べ方に指定はしませんでした。
調査項目 :・アンケート調査(毎日の排便状況、食事内容について)
・わかめを食べる前と後の腸内細菌の種類や存在割合を、糞便を回収して解析
【結果】
わかめの摂取による排便状況の改善
わかめを食べていた期間は、食べていなかった期間と比べて、排便量、回数、日数が顕著に増加した。
わかめ摂取によるおなかの中でのビフィズス菌の増加
わかめの摂取前と比較し、摂取後で糞便中のビフィズス菌の割合が上昇し、腸内フローラ注1)が変動することが明らかとなった。
わかめがビフィズス菌の生育に与える影響
おなかの中でビフィズス菌が増える理由を探るため、培養系を用いた検討を行った。通常、ビフィズス菌(Bifidobacterium longum)が生えない培地(コントロール培地)にわかめ粉末を混合させると、ビフィズス菌が生えるようになった(わかめ混合培地)。つまり、わかめがビフィズス菌(Bifidobacterium longum)の生育に役立っている可能性が示唆された。
本研究の結果からわかめを摂取することにより、排便状況の改善や腸内フローラの変動が認められたため、腸内環境が整えられることが期待される。
文献1)Hata Y., Nakaima K., Uchida J., Hidaka H., Nakano T. Clinical effects of brown seaweed, Undaria pinnatifida (wakame), on blood pressure in hypertensive subjects. J. Clin. Biochem. Nutr. 2001; 30: 43-53.
注1)腸内フローラ:個々の腸内細菌が集まって構築する微生物生態系のこと。ヒトの腸管内では多種•多様な細菌が絶えず増殖を続けており、腸内細菌の数はおよそ100兆個、その種類は一人あたり数百種にのぼるといわれ、その構成は食習慣や年齢などによって一人ひとり異なる。
<参考:食物繊維たっぷり!わかめ活用お手軽レシピ>
わかめとアボカドのスペイン風オムレツ
【食材(4人分)】
卵:5個
乾燥カットわかめ(乾燥のまま使用):10g
アボカド:1個
パルメザンチーズ:大さじ2
オリーブ油:大さじ2
トマトケチャップ:お好みで
イタリアンパセリ:少々
※食物繊維約3.2g(1人分)
【作り方】調理時間15分以内
①乾燥カットわかめは細かく砕き、溶きほぐした卵に加え戻しておく。
②アボカドは1.5cm角に切り、①に加え、パルメザンチーズも加え混ぜ合わせる。
③小さ目のフライパンにオリーブ油を熱し、②を流しいれ軽く混ぜながら中火で焼く。
④少しかたまってきたら器に一度取り裏返してふたをして弱火で5分程度焼く。
⑤器に取り切り分ける。イタリアンパセリやお好みでトマトケチャップを添える。
ズッキーニとわかめのファイバーサラダ
【食材(1皿分)】
ズッキーニ(黄) ※緑のものでも可:50g
乾燥カットわかめ:4g
冷凍枝豆(さやから外したもの):50g
サラダほうれん草:60g
スライスアーモンド(ロースト):8g
お好みのドレッシング:適量
※食物繊維約8.4g(一皿分)
【作り方】調理時間15分以
①乾燥カットわかめを水戻しし、しっかりと水気を切る。
②ズッキーニは薄く輪切りにし水にさらし、サラダほうれん草は3㎝程度に切る。
③器にわかめ・ズッキーニ・サラダほうれん草を盛り、枝豆・スライスアーモンドを散らす。
④お好みのドレッシングを回しかける。
理研ビタミン(株)は、今後とも天然物の有効利用について研究を進め、食を通じてお客様に健康と豊かな食生活を提供していく。
ちなみに理研ビタミン(株)(URL:http://www.rikenvitamin.jp/)は製造業で、本社を東京都千代田区神田三崎町2-9-18に置く。電話番号は03-5275-5111、代表者は山木一彦氏、上場は東証1部 資本金は25億3700万円。
URL:http://www.rikenvitamin.jp/corporate/technology/presentation.html

海藻はおよそ97%の人が「健康的である」というイメージを強くもっている食材(自社調べ)であるにもかかわらず、その健康効果については未解明な部分が多いのが実情だ。
理研ビタミンはこれまで、わかめの健康効果を明らかにすべく研究を重ね、血圧やコレステロールに対する影響など発表してきた文献1)。近年の研究から、生活習慣病の発症に腸内細菌が関与していることを示す研究が多く発表されていることなどから、今回はわかめの便通と腸内環境に与える影響をヒト試験で調べた。
【方法】
被験者 :週の排便日数が3-5日/週の便秘気味の女性21名の方
試験期間 :わかめを食べる前の2週間と、食べている2週間の合計4週間
試験食 :乾燥カットわかめ4g/日
※乾燥カットわかめは水戻しして食べる事以外、特に食べ方に指定はしませんでした。
調査項目 :・アンケート調査(毎日の排便状況、食事内容について)
・わかめを食べる前と後の腸内細菌の種類や存在割合を、糞便を回収して解析

【結果】
わかめの摂取による排便状況の改善
わかめを食べていた期間は、食べていなかった期間と比べて、排便量、回数、日数が顕著に増加した。

わかめ摂取によるおなかの中でのビフィズス菌の増加
わかめの摂取前と比較し、摂取後で糞便中のビフィズス菌の割合が上昇し、腸内フローラ注1)が変動することが明らかとなった。

わかめがビフィズス菌の生育に与える影響
おなかの中でビフィズス菌が増える理由を探るため、培養系を用いた検討を行った。通常、ビフィズス菌(Bifidobacterium longum)が生えない培地(コントロール培地)にわかめ粉末を混合させると、ビフィズス菌が生えるようになった(わかめ混合培地)。つまり、わかめがビフィズス菌(Bifidobacterium longum)の生育に役立っている可能性が示唆された。
本研究の結果からわかめを摂取することにより、排便状況の改善や腸内フローラの変動が認められたため、腸内環境が整えられることが期待される。
文献1)Hata Y., Nakaima K., Uchida J., Hidaka H., Nakano T. Clinical effects of brown seaweed, Undaria pinnatifida (wakame), on blood pressure in hypertensive subjects. J. Clin. Biochem. Nutr. 2001; 30: 43-53.
注1)腸内フローラ:個々の腸内細菌が集まって構築する微生物生態系のこと。ヒトの腸管内では多種•多様な細菌が絶えず増殖を続けており、腸内細菌の数はおよそ100兆個、その種類は一人あたり数百種にのぼるといわれ、その構成は食習慣や年齢などによって一人ひとり異なる。
<参考:食物繊維たっぷり!わかめ活用お手軽レシピ>
わかめとアボカドのスペイン風オムレツ

【食材(4人分)】
卵:5個
乾燥カットわかめ(乾燥のまま使用):10g
アボカド:1個
パルメザンチーズ:大さじ2
オリーブ油:大さじ2
トマトケチャップ:お好みで
イタリアンパセリ:少々
※食物繊維約3.2g(1人分)
【作り方】調理時間15分以内
①乾燥カットわかめは細かく砕き、溶きほぐした卵に加え戻しておく。
②アボカドは1.5cm角に切り、①に加え、パルメザンチーズも加え混ぜ合わせる。
③小さ目のフライパンにオリーブ油を熱し、②を流しいれ軽く混ぜながら中火で焼く。
④少しかたまってきたら器に一度取り裏返してふたをして弱火で5分程度焼く。
⑤器に取り切り分ける。イタリアンパセリやお好みでトマトケチャップを添える。
ズッキーニとわかめのファイバーサラダ

【食材(1皿分)】
ズッキーニ(黄) ※緑のものでも可:50g
乾燥カットわかめ:4g
冷凍枝豆(さやから外したもの):50g
サラダほうれん草:60g
スライスアーモンド(ロースト):8g
お好みのドレッシング:適量
※食物繊維約8.4g(一皿分)
【作り方】調理時間15分以
①乾燥カットわかめを水戻しし、しっかりと水気を切る。
②ズッキーニは薄く輪切りにし水にさらし、サラダほうれん草は3㎝程度に切る。
③器にわかめ・ズッキーニ・サラダほうれん草を盛り、枝豆・スライスアーモンドを散らす。
④お好みのドレッシングを回しかける。
理研ビタミン(株)は、今後とも天然物の有効利用について研究を進め、食を通じてお客様に健康と豊かな食生活を提供していく。
ちなみに理研ビタミン(株)(URL:http://www.rikenvitamin.jp/)は製造業で、本社を東京都千代田区神田三崎町2-9-18に置く。電話番号は03-5275-5111、代表者は山木一彦氏、上場は東証1部 資本金は25億3700万円。